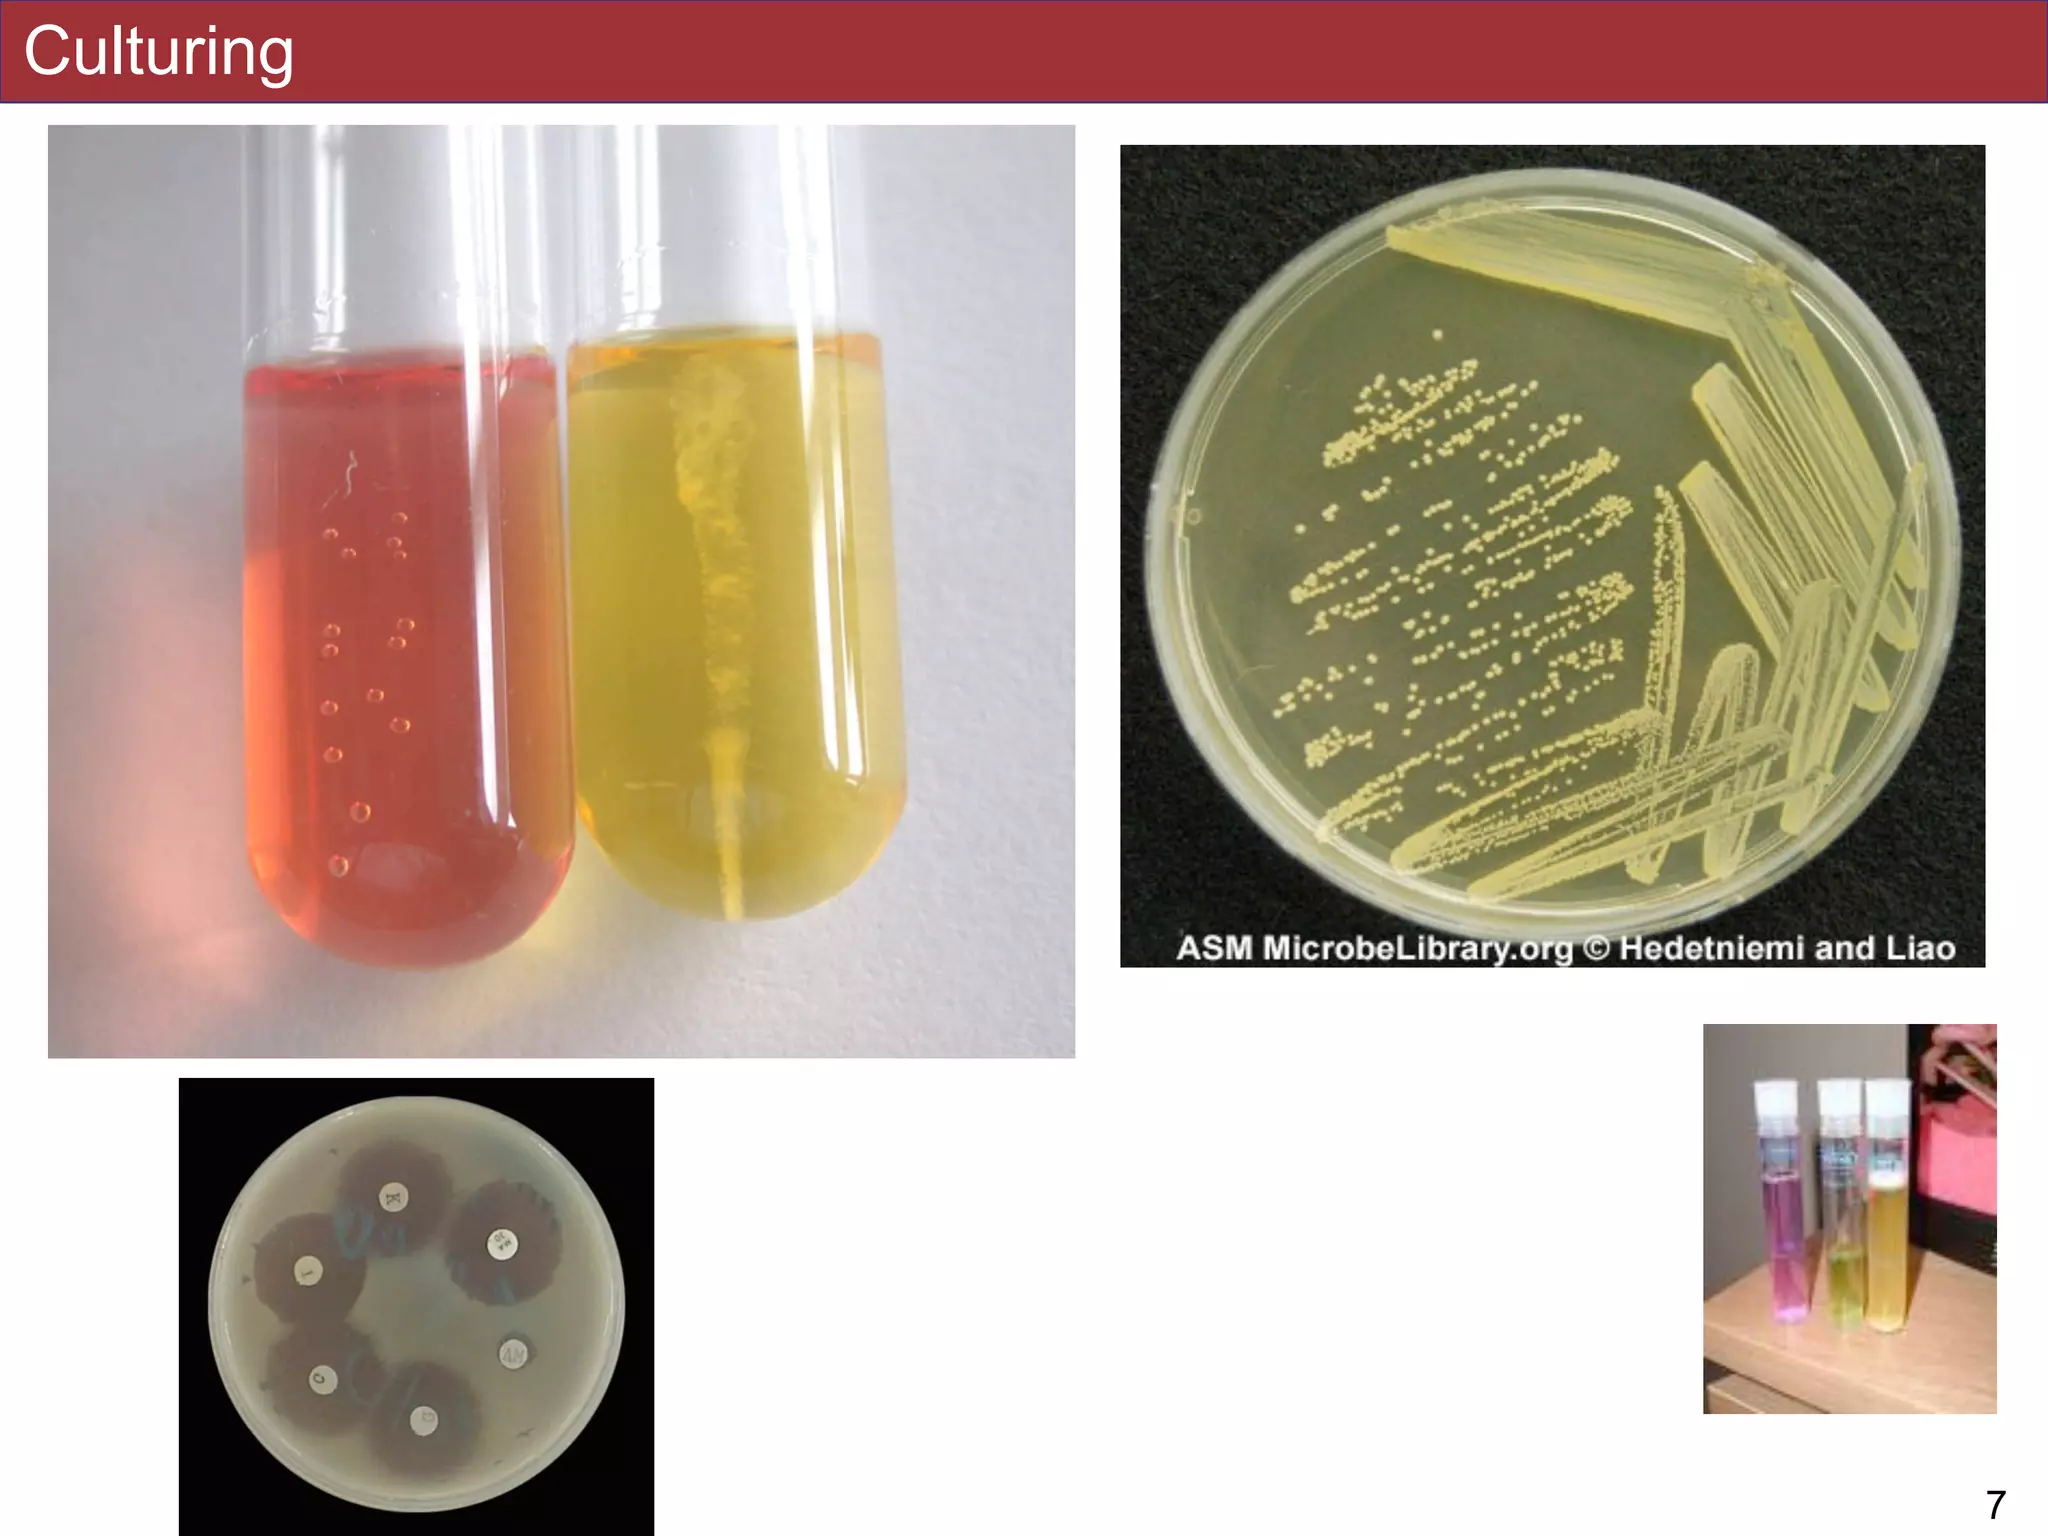
Culturing
!7

The document outlines a lecture on microbial growth and functions, focusing on culturing microorganisms in controlled conditions and their adaptations to extreme environments. Key concepts include extremophiles such as thermophiles and halophiles, their optimal growth conditions, and the different trophic strategies of microbes. The lecture also discusses the evolutionary implications of these adaptations and their practical applications in various fields.